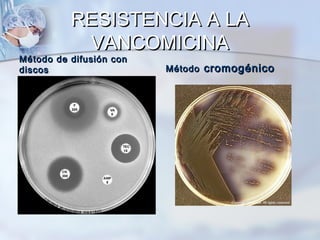
RESISTENCIA A LA
           VANCOMICINA
Método de difusión con
discos                   Método cromogénico

Este documento trata sobre la resistencia antimicrobiana y el papel del laboratorio de microbiología. Brevemente describe los mecanismos de resistencia de los microorganismos, el uso indiscriminado de antibióticos y los tratamientos prolongados. También cubre temas como la selección de antibióticos, los diferentes tipos de antibióticos y cómo actúan, así como los mecanismos de resistencia a los antibióticos beta-lactámicos. Finalmente, explica el papel del laboratorio de microbiología en la identificación de patógenos